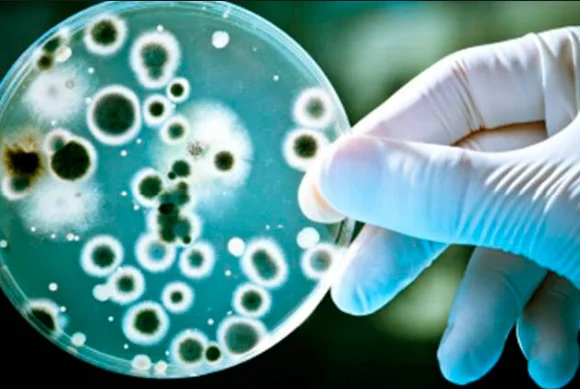
WellBlue пружинная и щелочная система фильтрации воды Kangen, щелочный ионизатор водяного фильтра

WellBlue пружинная и щелочная система фильтрации воды Kangen, щелочный ионизатор водяного фильтра
- Category: Water Treatment Appliances >>>
- Supplier: Shenzhen Landun Environmental Technology Co. Ltd.
Share on (60145149458):
Product Overview
Description
WellBlue Spring and Alkaline Kangen Water Filter system, Alkaline Ionizer Water Filter


5-Stage Filter Introduction:
stage 1: PP sediment filter
The filter precision is 5 microns, could remove rust, mud, sediment and large particles suspended solids from the water
stage 2: Coconut active carbon filter
Effectively removes the bad odor , chlorine from the water.
stage 3: Anti-scale block carbon filter
Deeply removes bad smell, color and scale from the water, improving water taste.
stage 4: UF membrane filter
UF membrane filter precision is 0.01 micron, could remove colloid, bacteria, virus and so on.
stage 5: Compound alkaline and rich-hydrogen filter
It changes water pH range, making the filtered water alkaline and anti-oxidant. pH is 9.5-10.5, ORP is -200mv~ - 350mv, Hydrogen is about 600-900. Besides, the filtered water include rich hydrogen inside, improving the balance acid and alkaline in human body, enhancing immunity.
Wellblue Alkaline water filters& water purifers Advantage:
1.NOT ONLY A WATER PURIFIER: We've used our mastery of technology to improve every other aspect of our life - so why should water be any different? And how can we get the different from RO water ? That's the line of thinking that led us to the creation of the WELLBLUE Alkaline Water Filter, and it can remove bacteria and virus, it is also mineralize alkaline water. Not only does it have great health benefits, it tastes also has a fresh and delicious natural taste!
2. GREATLY IMPROVED HYDRATION: By micro-clustering and reducing water molecule size, this great water purifier produces easily-absorbable alkaline water that will get you hydrated faster and more effectively. Filtered alkaline ionized water contains minimal free radicals and toxins, is a powerful antioxidant and enhances your energy levels and immune system.
3. COMPOSITE 5 STAGES FILTER CARTRIDGE: By utilizing a specially formulated 5-stages filter, the WELLBLUE Alkaline Water Purifier removes chlorine, heavy metals, baterial, Virus and other contaminants from water,and make the water softener, sets its pH to a basic value up to a 9pH depending on the source water. It also adds CALCIUM,MAGNESIUM, and potassium minerals and anti-oxidants, and provides a low negative ORP between -100 and -200 mv.
4. PREMIUM HEALTHY QUALITY: When it comes to our WELLBLUE Alkaline Water Filter , we make a point of using nothing but the finest materials available, as well as state-of-the-art manufacturing processes and strict quality control. 100% BPA-free, 100% Food grade materials, 100% recyclable, 100% vegan.
5. DOUBLE TAP DESIGN: Purified water could be used for wash vegetables, fruits, and kitchenwares. And alkaline water is for drinking, cooking. Prolong the alkaline water filter service life.
6. AMAZING CAPACITY: You don't have to worry about replacing your pitcher's filter every few weeks. The filters need to be replaced every 6-12 months.
ONE WATER PURIFIERS COULD HELP YOU TO SOLVE ALL OF THE WATER PROBLEMS.
BACTERIA PURIFIER
ALKALINE MACHINE WITH NO POWER
WATER SOFTENER
CHLORINE REMOVER

| Item | Wellblue hydrogen water filter | Other hydrogen maker |
| Power | No electricity | Electricity power is necessary |
| Principle | Physical filtration | Electrolysis |
| Filter function | High filter precision(0.01micron) | No filter function, only could produce hydrogen water |
| Feed water resource | Tap water | Pure water |
| Working time | Instantly, just need to open the faucet | It will take about at least 10 minutes |
| Usage | 2-way faucet | Only for drinking |
| One side is for purified water which is suitable for washing vegetables& fruits, cooking and so on. | ||
| Another is for drinking, coffee | ||
| Others | The filtered water is more healthy, tastes good | Possibly release chlorine in the water, harmful |
| Purchasing cost | Cheap | Expensive |












We Recommend
New Arrivals
New products from manufacturers at wholesale prices